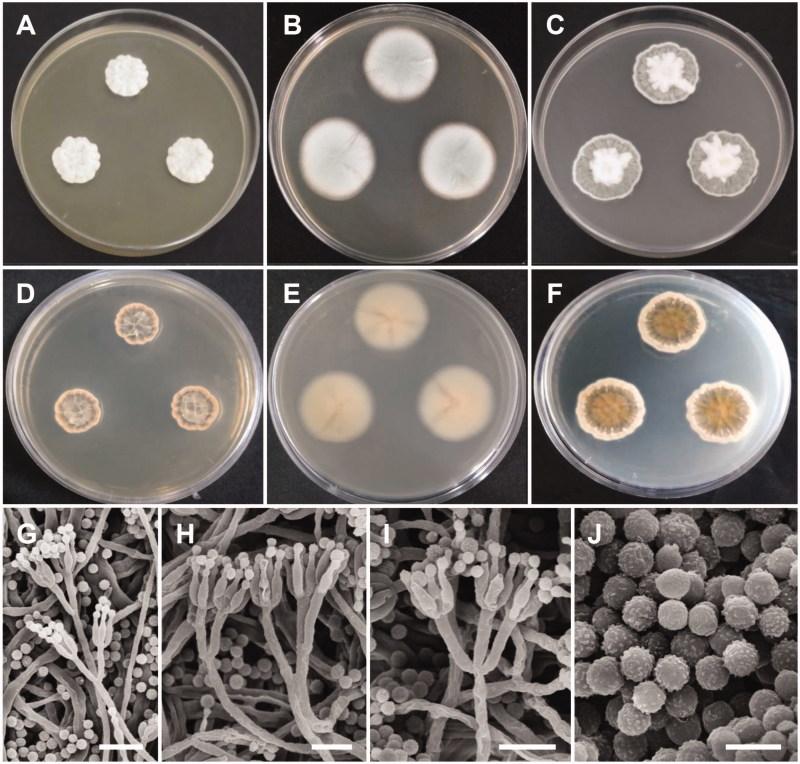
https://cdn.ncbi.nlm.nih.gov/pmc/blobs/5a52/6691828/d28214dacd55/TMYB_A_1554777_F0003_C.jpg

韩国土壤和淡水中散囊菌目四个物种的新记录
New Records of Four Species Belonging to Eurotiales from Soil and Freshwater in Korea.
作者信息
Pangging Monmi, Nguyen Thuong T T, Lee Hyang Burm
机构信息
Division of Food Technology, Biotechnology and Agrochemistry, College of Agriculture and Life Sciences, Chonnam National University, Gwangju, Korea.
出版信息
Mycobiology. 2019 Jan 14;47(2):154-164. doi: 10.1080/12298093.2018.1554777. eCollection 2019.
Four strains of and species are described and illustrated in an inventory of fungal species belonging to Eurotiales. The strains, CNUFC-DDS17-1, CNUFC-DDS27-1, CNUFC-PTM72-1, and CNUFC-YJW3-31, were isolated from soil and freshwater samples from South Korea. Based on their morphological characteristics and sequence analyses by the combined β-tubulin and calmodulin gene, the CNUFC-DDS17-1, CNUFC-DDS27-1, CNUFC-PTM72-1, and CNUFC-YJW3-31 isolates were identified as , , and , respectively. The designated strains were found to represent a previously undescribed species of Korean fungal biota. In this study, detailed morphological descriptions and phylogenetic relationships of these species are provided.
在一份属于曲霉目真菌物种的清单中描述并说明了四种曲霉属和青霉属物种。菌株CNUFC-DDS17-1、CNUFC-DDS27-1、CNUFC-PTM72-1和CNUFC-YJW3-31是从韩国的土壤和淡水样本中分离出来的。基于它们的形态特征以及通过β-微管蛋白和钙调蛋白基因联合进行的序列分析,分离出的CNUFC-DDS17-1、CNUFC-DDS27-1、CNUFC-PTM72-1和CNUFC-YJW3-31分别被鉴定为曲霉属、青霉属、曲霉属和青霉属。指定的菌株被发现代表了韩国真菌生物群中一个以前未描述过的物种。在本研究中,提供了这些物种的详细形态描述和系统发育关系。